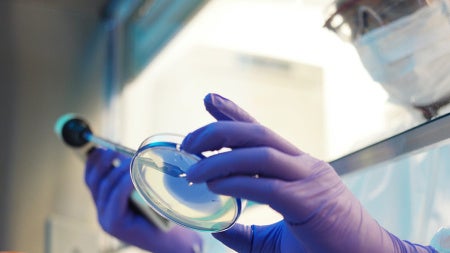
Cancer

Robert Salata arrived in Cleveland in the mid-1970s, ready to begin his MD studies at Case Western Reserve University School of Medicine. It was the start of a decades-long career in Cleveland that would have remarkable impact in understanding and preventing infectious diseases, not only in Northeast Ohio but around the world.
Today, members of the Case Western Reserve, University Hospitals (UH) and broader medical communities are mourning the loss of Salata, who died Aug. 26. He was 72.
A native of Youngstown, Ohio, Salata returned to Northeast Ohio to attend CWRU School of Medicine after earning his bachelor’s degree from the University of Notre Dame. After graduating from medical school in 1979, he completed his internship and residency in internal medicine at UH, then accepted a fellowship at the University of Virginia Medical Center, studying infectious disease. He returned to CWRU as an instructor and UH as chief resident in 1985—and never left.
In his 36 years on the faculty of Case Western Reserve School of Medicine, Salata served in various roles, including as the John H. Hord Professor and chairman of the Department of Medicine and founding director of the Infectious Diseases and Immunology Institute. He also held a joint role as chief of the Division of Infectious Diseases and HIV Medicine for nearly 20 years at CWRU and UH.
At UH, Salata was the STERIS Chair of Excellence in Medicine, physician-in-chief, distinguished physician, senior attending physician, chair of chairs and medical director of infection control and prevention at UH Cleveland Medical Center.
“But more important than his extensive titles was the difference he made as a physician, educator, mentor and colleague,” Dean Stan Gerson wrote to the School of Medicine community yesterday. “I was fortunate to work closely with Bob over many years, as division chiefs, during my tenure as UH Seidman Cancer Center director and even more so as dean while he was chair of the UH clinical chairs group. His equipoise, honesty and calm approach—even under stress—were a lesson to us all.”
This became increasingly evident during the COVID-19 pandemic, when his infectious disease expertise helped guide both UH and CWRU. He educated physicians and the public alike, providing insights in local and national media interviews and leading informative webinars. His renowned research in infectious disease was among the many reasons University Hospitals became site 001 for the clinical trial of Remdesivir, one of the first treatments for COVID-19; he went on to lead the trial for the Pfizer COVID mRNA vaccine in Northeast Ohio.
“In a time of crisis,” said Robert Bonomo, professor of medicine, “he led our community and country in preventive efforts by being on the leading edge of novel therapeutics and vaccines that were used around the world.”
COVID-19 was not Salata’s first global disease outbreak. In 1997, he began work as a principal investigator in HIV/AIDS research for the Uganda-Case Western Reserve University Research Collaboration—work that has continued ever since. Earlier this year, the university received a $2 million gift from The Roe Green Foundation, jointly awarded to CWRU and UH, to advance global health initiatives from each institution and establish a state-of-the-art research hub and gathering place in Uganda’s capital, Kampala.
“Bob was delighted to introduce new scientists to Uganda and create opportunities for them to work there,” said Jonathan Karn, professor and chair of the Department of Molecular Biology and Microbiology and director of the Center for AIDS Research. More than a decade ago, Karn noted, Salata organized a team of CWRU faculty and UH physicians to “perform the first balloon mitral valvuloplasty for rheumatic mitral stenosis and the first peripheral arterial stent implantation in Ugandan history.”
Two years later, at the peak of the Ebola outbreak in West Africa, Salata went to Sierra Leone to help. “I remember asking him whether this was wise,” Karn recalled, “but he just shrugged and said, ‘Don't worry, it's only Ebola!’”
Salata’s “abiding commitment to advancing health initiatives both in this country and abroad will be among his greatest accomplishments," said Case Western Reserve University President Eric W. Kaler.
Salata was a prolific researcher, earning continuous funding from the National Institutes of Health on a range of clinical trials, publishing hundreds of peer-reviewed publications and holding elected positions on national medical research committees.
But more than that, he is remembered for his immense impact as a colleague, mentor and educator.
“Bob’s lasting legacy—outside of his family—might be the generations of physicians he inspired and mentored,” said UH Chief Executive Officer Cliff A. Megerian. “Countless physicians have cited Dr. Salata’s clinical excellence, compassion and genuine interest in them as key factors that guided them through their most difficult moments of training and early academic career development.”
Bonomo is just one example. “Dr. Salata was the reason many of us pursued a career in medicine and spent our professional lives at CWRU, University Hospitals and the VA,” he said. “A consummate clinician with broad expertise, he taught trainees and colleagues how to care for patients in a manner that truly conveyed sincere compassion and concern.”
Michael Lederman, professor of medicine, noted Salata had “an encyclopedic knowledge and an extraordinarily organized efficiency. [H]e was a master at the bedside. He loved medicine—all of medicine—and his passion for it was reflected in his curiosity about the breadth of the field.”
Colleagues also noted his incredible commitment to his family. He is survived by his wife of 49 years, Jody; his four sons and daughters-in-law, Chris and Christy, Mike and Kristen, Andrew and Meagan, and Matt and Hayley; and 11 grandchildren.
Among Karn’s fondest memories of Salata was a 2004 School of Medicine graduation ceremony, where Salata hooded his son, Michael, and Anthony Fauci delivered the school’s keynote address on why people should work on infectious diseases. “It was an occasion,” Karn noted, “that embodied Bob's devotion to infectious diseases, his pride in his family and his career-long engagement with CWRU.”
Services will be held Friday, Aug. 30, at 11 a.m. at Church of the Gesu (2470 Miramar Blvd., University Heights); a private interment will also be held. Access the livestream. His full obituary is available online.
Students who would like support during this time are encouraged to contact University Health and Counseling Services at 216.368.5872. This line is staffed by a counselor 24 hours a day, seven days a week. Faculty and staff can access counseling at any time by calling IMPACT Solutions at 1.800.227.6007.